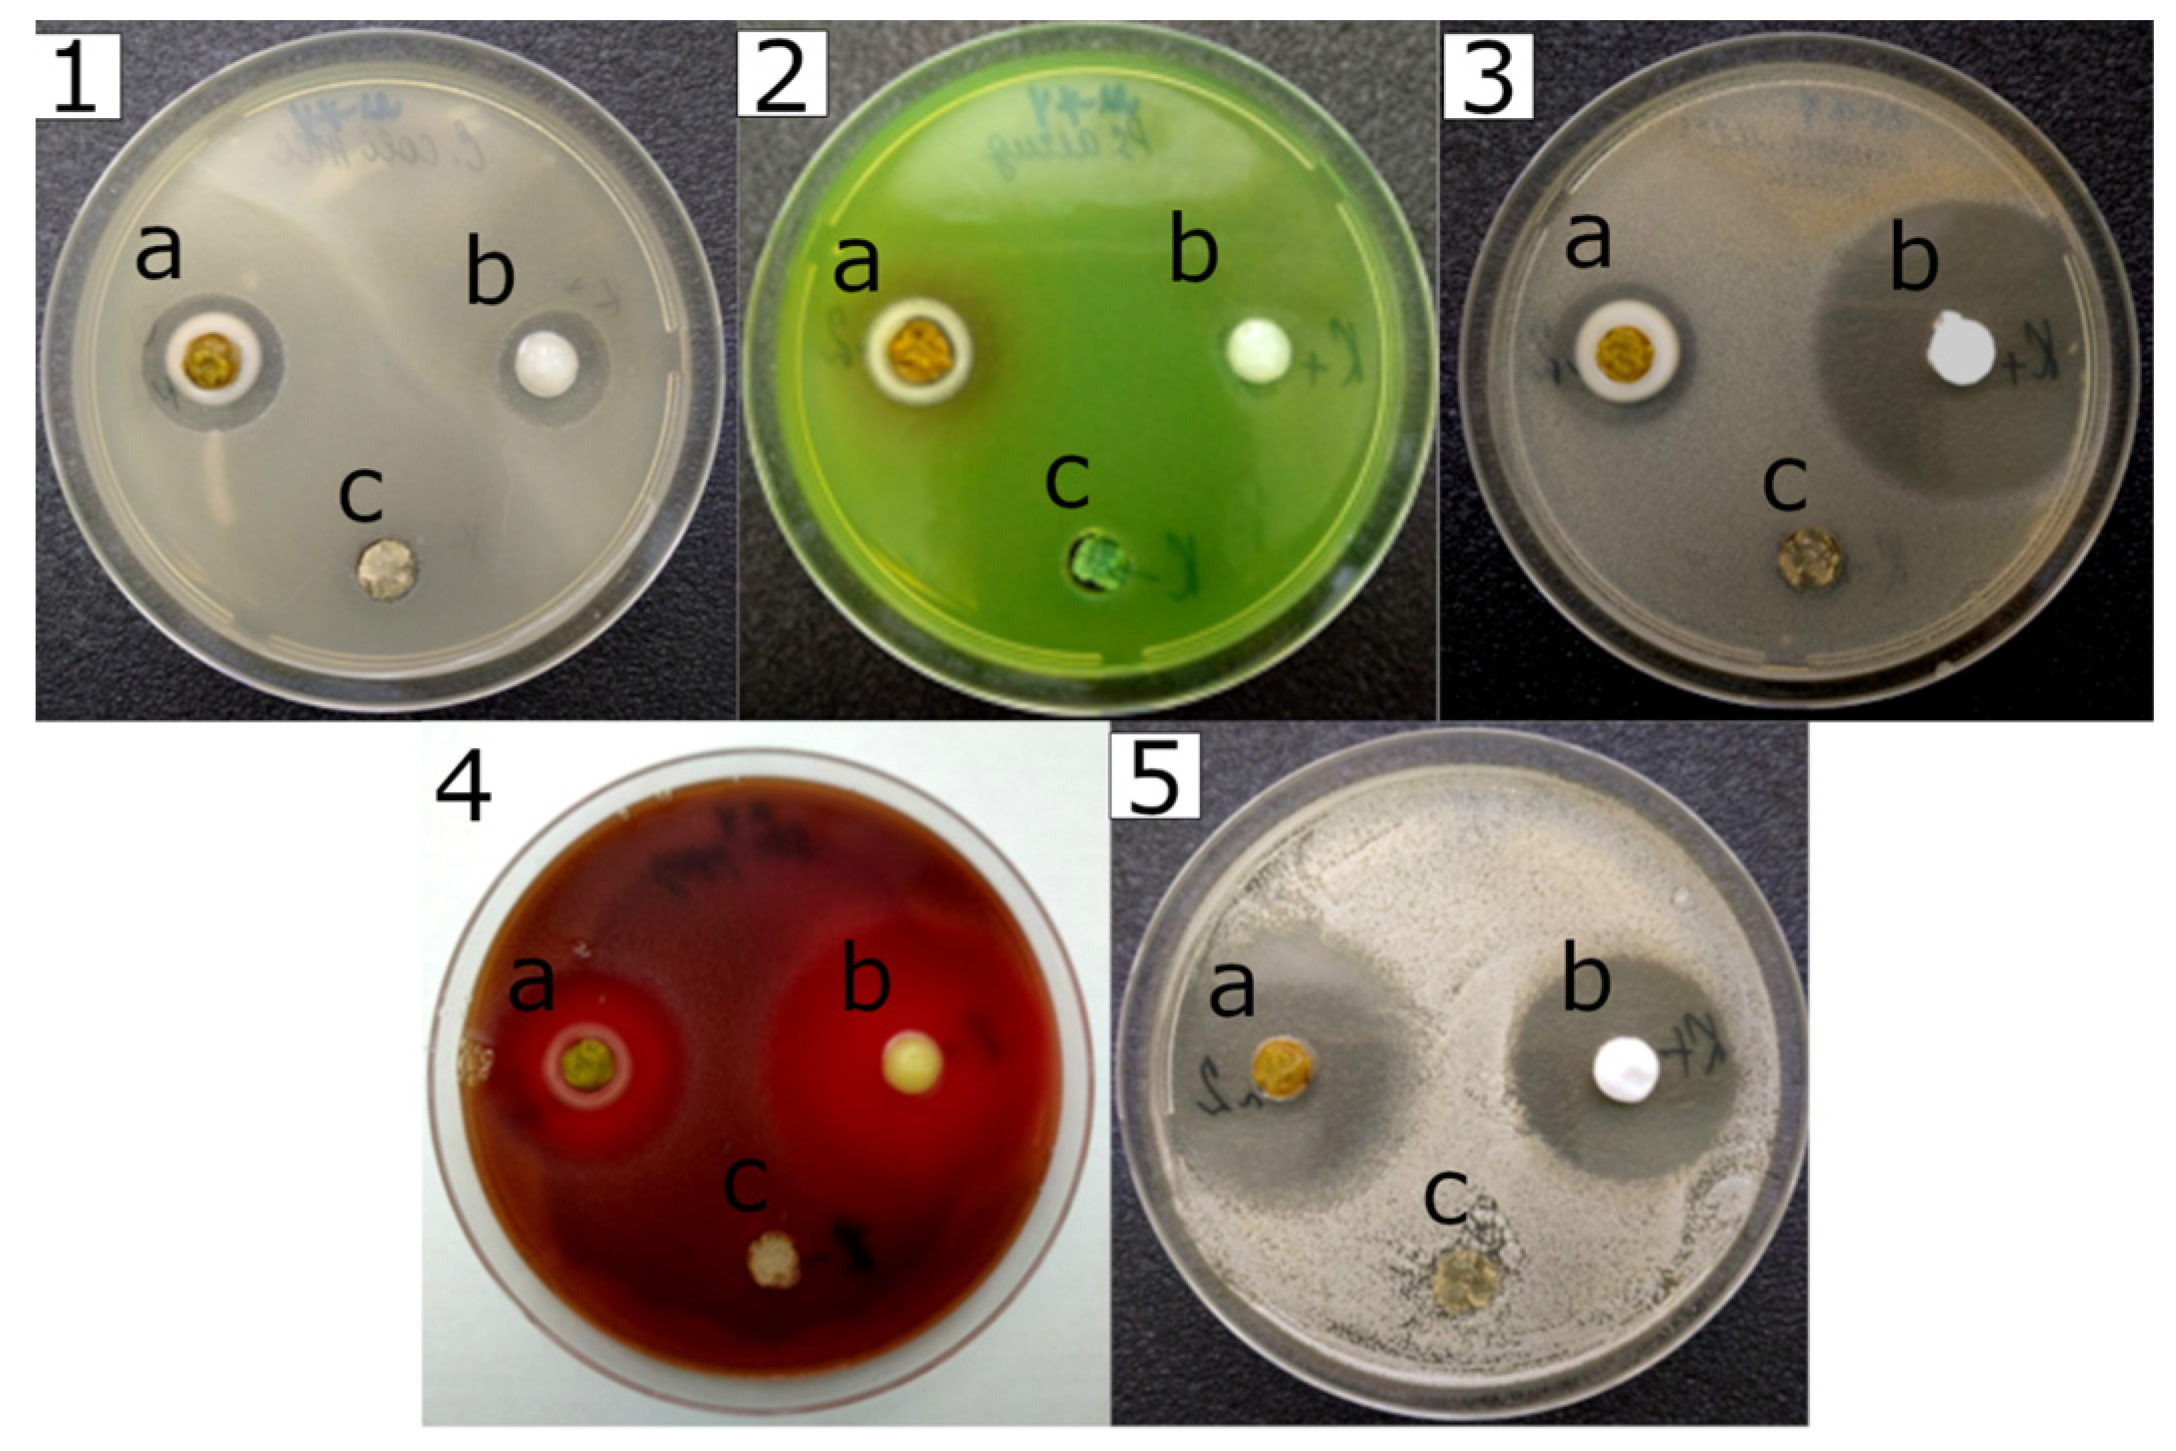
Gels 10 00795 g009

Hemostatic Antimicrobial Hydrogels Based on Silicon, Iron, Zinc, and Boron Glycerolates for Wound Healing Applications
Abstract
1. Introduction
2. Results and Discussion
2.1. Characteristics of Glycerolates Precursors
2.2. Preparation of Glycerohydrogels
2.3. Rheological Properties
2.4. FTIR Analysis
2.5. TEM Analysis
2.6. TGA
2.7. AES Analysis
2.8. ESI MS Analysis
2.9. XRD Analysis
2.10. Pharmacological Studies
2.10.1. Toxicological Profile of Glycerohydrogels
2.10.2. Hemostatic Properties of Glycerolates Hydrogels
2.10.3. Antimicrobial Properties of Glycerolates Hydrogels
3. Conclusions
4. Materials and Methods
4.1. Materials
4.2. Synthesis of Glycerolate Precursors
4.2.1. Synthesis of Silicon Tetraglycerolate Si(C3H7O3)4 in Excess of Glycerol
4.2.2. Synthesis of Iron(III) Monoglycerolate FeC3H5O3
4.2.3. Synthesis of Zinc Monoglycerolate ZnC3H6O3 in 6 M Excess of Glycerol
4.2.4. Synthesis of Boron Bisglycerolates HB(C3H6O3)2
4.3. Synthesis of Hydrogels
4.3.1. Synthesis of Si-Fe–Gel
4.3.2. Synthesis of Si-Fe-Zn–Gel
4.3.3. Synthesis of Si-Fe-B–Gel
4.3.4. Synthesis of Si-Fe-Zn-B–Gel
4.4. Separation of Dispersed (Solid) Phase and Dispersion (Liquid) Medium of Studied Hydrogel
4.5. Hydrogel’s Characterization
4.6. Pharmacological Studies
4.6.1. Toxicological Study
Acute Toxicity Study
Skin Irritating Properties
Local Irritant Effect
Skin-Resorptive Effect
Sensitizing Effect
4.6.2. Hemostatic Study
4.6.3. Antimicrobial Study
4.7. Statistical Analysis
Author Contributions
Funding
Institutional Review Board Statement
Informed Consent Statement
Data Availability Statement
Acknowledgments
Conflicts of Interest
References
- Peng, H.T. Hemostatic Agents for Prehospital Hemorrhage Control: A Narrative Review. Mil. Med. Res. 2020, 7, 13. [Google Scholar] [CrossRef] [PubMed]
- Han, W.; Wang, S. Advances in Hemostatic Hydrogels That Can Adhere to Wet Surfaces. Gels 2023, 9, 2. [Google Scholar] [CrossRef] [PubMed]
- Yu, P.; Zhong, W. Hemostatic Materials in Wound Care. Burns Trauma 2021, 9, tkab019. [Google Scholar] [CrossRef] [PubMed]
- Wang, L.; You, X.; Dai, C.; Tong, T.; Wu, J. Hemostatic Nanotechnologies for External and Internal Hemorrhage Management. Biomater. Sci. 2020, 8, 4396–4412. [Google Scholar] [CrossRef]
- Ribeiro, M.; Simões, M.; Vitorino, C.; Mascarenhas-Melo, F. Hydrogels in Cutaneous Wound Healing: Insights into Characterization, Properties, Formulation and Therapeutic Potential. Gels 2024, 10, 188. [Google Scholar] [CrossRef] [PubMed]
- Yang, Y.; Liang, Y.; Chen, J.; Duan, X.; Guo, B. Mussel-Inspired Adhesive Antioxidant Antibacterial Hemostatic Composite Hydrogel Wound Dressing via Photo-polymerization for Infected Skin Wound Healing. Bioact. Mater. 2022, 8, 341–354. [Google Scholar] [CrossRef]
- Liu, L.; Hu, E.; Yu, K.; Xie, R.; Lu, F.; Lu, B.; Bao, R.; Li, Q.; Dai, F.; Lan, G. Recent Advances in Materials for Hemostatic Management. Biomater. Sci. 2021, 9, 7343–7378. [Google Scholar] [CrossRef]
- Simpson, A.; Shukla, A.; Brown, A.C. Biomaterials for Hemostasis. Annu. Rev. Biomed. Eng. 2022, 24, 111–135. [Google Scholar] [CrossRef]
- Guo, B.; Dong, R.; Liang, Y.; Li, M. Haemostatic Materials for Wound Healing Applications. Nat. Rev. Chem. 2021, 5, 773–791. [Google Scholar] [CrossRef]
- Alves, P.; Luzio, D.; de Sá, K.; Correia, I.; Ferreira, P. Preparation of Gel Forming Polymer-Based Sprays for First Aid Care of Skin Injuries. Gels 2024, 10, 297. [Google Scholar] [CrossRef]
- Das, S.K.; Parandhaman, T.; Dey, M.D. Biomolecule-Assisted Synthesis of Biomimetic Nanocomposite Hydrogel for Hemostatic and Wound Healing Applications. Green Chem. 2021, 23, 629–669. [Google Scholar] [CrossRef]
- Fan, P.; Zeng, Y.; Zaldivar-Silva, D.; Agüero, L.; Wang, S. Chitosan-Based Hemostatic Hydrogels: The Concept, Mechanism, Application, and Prospects. Molecules 2023, 28, 1473. [Google Scholar] [CrossRef] [PubMed]
- Liu, Y.; Su, G.; Zhang, R.; Dai, R.; Li, Z. Nanomaterials-Functionalized Hydrogels for the Treatment of Cutaneous Wounds. Int. J. Mol. Sci. 2023, 24, 336. [Google Scholar] [CrossRef]
- Ijaz, F.; Tahir, H.M.; Ali, S.; Ali, A.; Khan, H.A.; Muzamil, A.; Manzoor, H.H.; Qayyum, K.A. Biomolecules Based Hydrogels and Their Potential Biomedical Applications: A Comprehensive Review. Int. J. Biol. Macromol. 2023, 253, 127362. [Google Scholar] [CrossRef] [PubMed]
- Liang, Y.; He, J.; Guo, B. Functional Hydrogels as Wound Dressing to Enhance Wound Healing. ACS Nano 2021, 15, 12687–12722. [Google Scholar] [CrossRef] [PubMed]
- Ho, T.-C.; Chang, C.-C.; Chan, H.-P.; Chung, T.-W.; Shu, C.-W.; Chuang, K.-P.; Duh, T.-H.; Yang, M.-H.; Tyan, Y.-C. Hydrogels: Properties and Applications in Biomedicine. Molecules 2022, 27, 2902. [Google Scholar] [CrossRef] [PubMed]
- Oliveira, C.; Sousa, D.; Teixeira, J.A.; Ferreira-Santos, P.; Botelho, C.M. Polymeric Biomaterials for Wound Healing. Front. Bioeng. Biotechnol. 2023, 11, 1136077. [Google Scholar] [CrossRef]
- Parfenyuk, E.V.; Dolinina, E.S. Silica Hydrogel Composites as a Platform for Soft Drug Formulations and Cosmetic Compositions. Mater. Chem. Phys. 2022, 287, 126160. [Google Scholar] [CrossRef]
- Fan, F.; Saha, S.; Hanjaya-Putra, D. Biomimetic Hydrogels to Promote Wound Healing. Front. Bioeng. Biotechnol. 2021, 9, 718377. [Google Scholar] [CrossRef]
- Chen, S.; Yang, K.; Chen, M.; Leng, X.; Wang, Q.; Lin, M.; Ivanov, A.; Zhang, P.; Andreeva, D.V. Chapter 12—Bioinspired, Biomimetic Hydrogels. In Sustainable Hydrogels; Thomas, S., Sharma, B., Jain, P., Shekhar, S., Eds.; Elsevier: Amsterdam, The Netherlands, 2023; pp. 325–354. ISBN 978-0-323-91753-7. [Google Scholar]
- Ciulla, M.G.; Massironi, A.; Sugni, M.; Ensign, M.A.; Marzorati, S.; Forouharshad, M. Recent Advances in the Development of Biomimetic Materials. Gels 2023, 9, 833. [Google Scholar] [CrossRef]
- González, L.; Espinoza, V.; Tapia, M.; Aedo, V.; Ruiz, I.; Meléndrez, M.; Aguayo, C.; Atanase, L.I.; Fernández, K. Innovative Approach to Accelerate Wound Healing: Synthesis and Validation of Enzymatically Cross-linked COL–rGOBiocomposite Hydrogels. Gels 2024, 10, 448. [Google Scholar] [CrossRef] [PubMed]
- Rana, M.M.; De la Hoz Siegler, H. Evolution of Hybrid Hydrogels: Next-Generation Biomaterials for Drug Delivery and Tissue Engineering. Gels 2024, 10, 216. [Google Scholar] [CrossRef] [PubMed]
- Singh, V.; Srivastava, P.; Singh, A.; Singh, D.; Malviya, T. Polysaccharide-Silica Hybrids: Design and Applications. Polym. Rev. 2016, 56, 113–136. [Google Scholar] [CrossRef]
- Salama, A. Polysaccharides/Silica Hybrid Materials: New Perspectives for Sustainable Raw Materials. J. Carbohydr. Chem. 2016, 35, 131–149. [Google Scholar] [CrossRef]
- Shchipunov, Y. Biomimetic Sol–Gel Chemistry to Tailor Structure, Properties, and Functionality of Bionanocomposites by Biopolymers and Cells. Materials 2024, 17, 224. [Google Scholar] [CrossRef]
- Kickelbick, G. Introduction to Sol-Gel Nanocomposites. In Sol-Gel Nanocomposites; Guglielmi, M., Kickelbick, G., Martucci, A., Eds.; Springer: New York, NY, USA, 2014; pp. 1–19. ISBN 978-1-4939-1209-4. [Google Scholar]
- Owens, G.J.; Singh, R.K.; Foroutan, F.; Alqaysi, M.; Han, C.-M.; Mahapatra, C.; Kim, H.-W.; Knowles, J.C. Sol–Gel Based Materials for Biomedical Applications. Prog. Mater. Sci. 2016, 77, 1–79. [Google Scholar] [CrossRef]
- Bokov, D.; Jalil, A.T.; Chupradit, S.; Suksatan, W.; Ansari, M.J.; Shewael, I.H.; Valiev, G.H.; Kianfar, E. Nanomaterial by Sol-Gel Method: Synthesis and Application. Adv. Mater. Sci. Eng. 2021, 2021, 5102014. [Google Scholar] [CrossRef]
- Klein, L.; Aparicio, M.; Jitianu, A. Handbook of Sol-Gel Science and Technology; Springer: Cham, Switzerland, 2018; ISBN 978-3-319-19454-7. [Google Scholar]
- Pierre, A.C. Introduction to Sol-Gel Processing; Springer: Cham, Switzerland, 2020; ISBN 978-3-030-38144-8. [Google Scholar]
- Gill, I.; Ballesteros, A. Encapsulation of Biologicals within Silicate, Siloxane, and Hybrid Sol-Gel Polymers: An Efficient and Generic Approach. J. Am. Chem. Soc. 1998, 120, 8587–8598. [Google Scholar] [CrossRef]
- Brook, M.A.; Chen, Y.; Guo, K.; Zhang, Z.; Brennan, J.D. Sugar-Modified Silanes: Precursors for Silica Monoliths. J. Mater. Chem. 2004, 14, 1469–1479. [Google Scholar] [CrossRef]
- Brandhuber, D.; Torma, V.; Raab, C.; Peterlik, H.; Kulak, A.; Hüsing, N. Glycol-Modified Silanes in the Synthesis of Mesoscopically Organized Silica Monoliths with Hierarchical Porosity. Chem. Mater. 2005, 17, 4262–4271. [Google Scholar] [CrossRef]
- Shchipunov, Y.A.; Karpenko, T.Y.; Krekoten, A.V.; Postnova, I.V. Gelling of Otherwise Nongelable Polysaccharides. J. Colloid Interface Sci. 2005, 287, 373–378. [Google Scholar] [CrossRef] [PubMed]
- Wang, G.H.; Zhang, L.M. A Biofriendly Silica Gel for in Situ Protein Entrapment: Biopolymer-Assisted Formation and its Kinetic Mechanism. J. Phys. Chem. B 2009, 113, 2688–2694. [Google Scholar] [CrossRef] [PubMed]
- Khonina, T.G.; Safronov, A.P.; Shadrina, E.V.; Ivanenko, M.V.; Suvorova, A.I.; Chupakhin, O.N. Mechanism of Structural Networking in Hydrogels Based on Silicon and Titanium Glycerolates. J. Colloid Interface Sci. 2012, 365, 81–89. [Google Scholar] [CrossRef] [PubMed]
- Khonina, T.G.; Safronov, A.P.; Ivanenko, M.V.; Shadrina, E.V.; Chupakhin, O.N. Features of Silicon– and Titanium–Polyethylene Glycol Precursors in Sol–Gel Synthesis of New Hydrogels. J. Mater. Chem. B 2015, 3, 5490–5500. [Google Scholar] [CrossRef] [PubMed]
- Feinle, A.; Elsaesser, M.S.; Hüsing, N. Sol-Gel Synthesis of Monolithic Materials with Hierarchical Porosity. Chem. Soc. Rev. 2016, 45, 3377–3399. [Google Scholar] [CrossRef]
- Wang, G.H.; Zhang, L.M. Electroactive Polyaniline/Silica Hybrid Gels: Controllable Sol-Gel Transition Adjusted by Chitosan Derivatives. Carbohydr. Polym. 2018, 202, 523–529. [Google Scholar] [CrossRef] [PubMed]
- Chen, Y.; Brook, M.A. Starch-Directed Synthesis of Worm-shaped Silica Microtubes. Materials 2023, 16, 2831. [Google Scholar] [CrossRef]
- Lavrova, D.G.; Zvonarev, A.N.; Alferov, V.A.; Khonina, T.G.; Shadrina, E.V.; Alferov, S.V.; Ponamoreva, O.N. Biocompatible Silicapolyethylene Glycol-Based Composites for Immobilization of Microbial Cells by Sol-Gel Synthesis. Polymers 2023, 15, 458. [Google Scholar] [CrossRef] [PubMed]
- Khonina, T.G.; Ivanenko, M.V.; Chupakhin, O.N.; Safronov, A.P.; Bogdanova, E.A.; Karabanalov, M.S.; Permikin, V.V.; Larionov, L.P.; Drozdova, L.I. Silicon-Zinc-Glycerol Hydrogel, a Potential Immunotropic Agent for Topical Application. Eur. J. Pharm. Sci. 2017, 107, 197–202. [Google Scholar] [CrossRef]
- Khonina, T.G.; Kungurov, N.V.; Zilberberg, N.V.; Evstigneeva, N.P.; Kokhan, M.M.; Polishchuk, A.I.; Shadrina, E.V.; Nikitina, E.Y.; Permikin, V.V.; Chupakhin, O.N. Structural Features and Antimicrobial Activity of Hydrogels Obtained by the Sol–Gel Method from Silicon, Zinc, and Boron Glycerolates. J. Sol-Gel Sci. Technol. 2020, 95, 682–692. [Google Scholar] [CrossRef]
- Khonina, T.G.; Safronov, A.P.; Bulatova, M.A.; Larionov, L.P.; Antropova, I.P.; Dobrinskaya, M.N.; Izmozherova, N.V.; Tishin, D.S.; Alekseenko, S.G.; Bogdanova, E.A.; et al. Iron(III) Monoglycerolate: A Potential Hemostatic Agent for Topical Application. Curr. Bioact. Compd. 2025, 21, e090524229805. [Google Scholar] [CrossRef]
- Khonina, T.G.; Tishin, D.S.; Larionov, L.P.; Osipenko, A.V.; Dobrinskaya, M.N.; Bogdanova, E.A.; Karabanalov, M.S.; Bulatova, M.A.; Shadrina, E.V.; Chupakhin, O.N. Iron(III)Monoglycerolate as a New Biocompatible Precursor in the Synthesis of Bioactive Nanocomposite Glycerohydrogels. Curr. Pharm. Biotechnol. 2024, 25, 2022–2031. [Google Scholar] [CrossRef]
- Khonina, T.G.; Tishin, D.S.; Larionov, L.P.; Dobrinskaya, M.N.; Antropova, I.P.; Izmozherova, N.V.; Osipenko, A.V.; Shadrina, E.V.; Nikitina, E.Y.; Bogdanova, E.A.; et al. Bioactive Silicon-Iron-Containing Glycerohydrogel Synthesized by the Sol-gel Method in the Presence of Chitosan. Russ. Chem. Bull. 2022, 71, 2342–2351. [Google Scholar] [CrossRef]
- Chiappe, C.; Signori, F.; Valentini, G.; Marchetti, L.; Pomelli, C.S.; Bellina, F. Novel (Glycerol)borate-Based Ionic Liquids: An Experimental and Theoretical Study. J. Phys. Chem. B 2010, 114, 5082–5088. [Google Scholar] [CrossRef]
- Plasseraud, L. Glycerol as Ligand in Metal Complexes—A Structural Review. Crystals 2024, 14, 217. [Google Scholar] [CrossRef]
- Cheong, M.Y.; Hazimah, A.H.; Zafarizal, A.A.H.; Rosnah, I. Zinc Glycerolate: Potential Active for Topical Application. J. Oil Palm. Res. 2012, 24, 1287–1295. [Google Scholar]
- Khonina, T.G.; Nikitina, E.Y.; Germov, A.Y.; Goloborodsky, B.Y.; Mikhalev, K.N.; Bogdanova, E.A.; Tishin, D.S.; Demin, A.M.; Krasnov, V.P.; Chupakhin, O.N.; et al. Individual Iron(III) Glycerolate: Synthesis and Characterisation. RSC Adv. 2022, 12, 4042–4046. [Google Scholar] [CrossRef]
- Riaz, M.; Zaman, M.; Hameed, H.; Sarwar, H.S.; Khan, M.A.; Irfan, A.; Shazly, G.A.; Paiva-Santos, A.C.; Bin Jardan, Y.A. Lamotrigine-Loaded Poloxamer-Based Thermo-Responsive Sol–Gel: Formulation, in Vitro Assessment, ex Vivo Permeation, and Toxicology Study. Gels 2023, 9, 817. [Google Scholar] [CrossRef]
- Lau, P.-C.; Kwong, T.-L.; Yung, K.-F. Effective Heterogeneous Transition Metal Glycerolates Catalysts for One-Step Biodiesel Production from Low Grade Non-Refined Jatropha Oil and Crude Aqueous Bioethanol. Sci. Rep. 2016, 6, 23822. [Google Scholar] [CrossRef]
- Mironov, A.N. Guidelines for Preclinical Trials of Drugs; Grifi K: Moscow, Russia, 2012. [Google Scholar]
- Oliva, N.; Conde, J.; Wang, K.; Artzi, N. Designing Hydrogels for On-demand Therapy. AccChem Res. 2017, 50, 669–679. [Google Scholar] [CrossRef]
- Kheirabadi, B.S.; Sieber, J.; Bukhari, T.; Rudnicka, K.; Murcin, L.A.; Tuthill, D. High-Pressure Fibrin Sealant Foam: An Effective Hemostatic Agent for Treating Severe Parenchymal Hemorrhage. J. Surg. Res. 2008, 144, 145–150. [Google Scholar] [CrossRef]
- Takács, I.; Wegmann, J.; Horváth, S.; Ferencz, A.; Ferencz, S.; Jávor, S.; Odermatt, E.; Rõth, E.; Weber, G. Efficacy of Different Hemostatic Devices for Severe Liver Bleeding: A Randomized Controlled Animal Study. Surg. Innov. 2010, 17, 346–352. [Google Scholar] [CrossRef]
- Nuvvula, S.; Bandi, M.; Mallineni, S.K. Clinical Applications of Ferric Sulfate in Dentistry: A Narrative Review. J. Conserv. Dent. 2017, 20, 278–281. [Google Scholar] [CrossRef]
- Nouri, S.; Sharif, M.R.; Jamali, B.; Panahi, Y. Effect of Ferric Sulfate and Ferric Chloride in Controlling Liver Bleeding an Animal Model Study. Physiol. Pharmacol. 2015, 18, 429–436. [Google Scholar]
- Tran, H.D.N.; Moonshi, S.S.; Xu, Z.P.; Ta, H.T. Influence of Nanoparticles on the Haemostatic Balance: Between Thrombosis and Haemorrhage. Biomater. Sci. 2021, 10, 10–50. [Google Scholar] [CrossRef]
- Jain, J.; Arora, S.; Rajwade, J.M.; Omray, P.; Khandelwal, S.; Paknikar, K.M. Silver Nanoparticles in Therapeutics: Development of an Antimicrobial Gel Formulation for Topical Use. Mol. Pharm. 2009, 6, 1388–1401. [Google Scholar] [CrossRef]
- Qu, J.; Pei, L.; Wang, X.; Fu, S.; Yong, L.; Xiao, X.; Xie, Q.; Fan, B.; Song, Y. Acute and Subchronic Oral Toxicity of Anthraquinone in Sprague Dawley Rats. Int. J. Environ. Res. Public Health 2022, 19, 10413. [Google Scholar] [CrossRef]
- Zainal, Z.; Ong, A.; Yuen May, C.; Chang, S.K.; Abdul Rahim, A.; Khaza’ai, H. Acute and Subchronic Oral Toxicity of Oil Palm Puree in Sprague-Dawley Rats. Int. J. Environ. Res. Public Health 2020, 17, 3404. [Google Scholar] [CrossRef]
- Nalimu, F.; Oloro, J.; Peter, E.L.; Ogwang, P.E. Acute and Sub-acute Oral Toxicity of Aqueous Whole Leaf and Green Rind Extracts of Aloe Vera in Wistar Rats. BMC Complement. Med. Ther. 2022, 22, 16. [Google Scholar] [CrossRef]
- Babul, N.; Rehni, A.; Singh, A.; Kao, H.; Bajaj, A. Skin Irritation Potential of Topical Mepivacaine Gel and Cream Dosage Forms. J. Pain Res. 2012, 13, 446. [Google Scholar] [CrossRef]
- Chen, H.; Chen, Z.; Xu, Y. Short-Term Ocular Toxicity and Eye Irritation Tests Following Application of Sufentanil in Rabbits. Eye Sci. 2014, 29, 193–197. [Google Scholar] [PubMed]
- Xiang, C.; Yang, G.; Yang, B.; Zheng, C.; Zhou, J.; Li, Z. Study on Skin Irritation of Clobetasone Butyrate Cream in Rabbits and its Skin Sensitization in Guinea Pigs. China Pharm. 2020, 12, 330–334. [Google Scholar]
- Kopec, A.K.; Joshi, N.; Luyendyk, J.P. Role of Hemostatic Factors in Hepatic Injury and Disease: Animal Models Deliver. J. Thromb. Haemost. 2016, 14, 1337–1349. [Google Scholar] [CrossRef] [PubMed]
- Gao, Y.; Ikeda-Imafuku, M.; Zhao, Z.; Joshi, M.; Mitragotri, S. A Polymer-Based Systemic Hemostat for Managing Uncontrolled Bleeding. Bioeng. Transl. Med. 2023, 8, e10516. [Google Scholar] [CrossRef]
- Balouiri, M.; Sadiki, M.; Ibnsouda, S.K. Methods for in Vitro Evaluating Antimicrobial Activity: A Review. J. Pharm. Anal. 2016, 6, 71–79. [Google Scholar] [CrossRef]

| Gel | Gel Components (mol) | Reaction Time at 70 °C (min) | |||||
|---|---|---|---|---|---|---|---|
| Si(C3H7O3)4 | FeC3H5O3 | ZnC3H6O3 | HB(C3H6O3)2 | C3H8O3 | H2O | ||
| Si-Fe–Gel * | 1.00 | 0.30 | − | − | 3.00 | 24.00 | 90 |
| Si-Fe-Zn–Gel | 1.00 | 0.25 | 0.50 | − | 11.00 | 25.00 | 15 |
| Si-Fe-B–Gel | 1.00 | 0.25 | − | 1.00 | 8.00 | 25.00 | 540 |
| Si-Fe-Zn-B–Gel | 1.00 | 0.25 | 0.25 | 0.50 | 6.00 | 25.00 | 15 |
| Gel | 1st Decomposition Step | 2nd Decomposition Step | 3rd Decomposition Step | M1000 ** (%) | |||
|---|---|---|---|---|---|---|---|
| Weight Loss (%) | Tmax * (°C) | Weight Loss (%) | Tmax (°C) | Weight Loss (%) | Tmax (°C) | ||
| Si-Fe–Gel | 23.1 | 88 | 63.7 | 238 | 6.3 | 350 | 6.9 |
| Si-Fe-Zn–Gel | 19.4 | 84 | 66.5 | 241 | 7.5 | 346, 389 | 6.6 |
| Si-Fe-B–Gel | 9.8 | − | 77.0 | 240 | 6.3 | 352 | 6.9 |
| Si-Fe-Zn-B–Gel | 24.8 | 78 | 56.1 | 233 | 10.2 | 342 | 8.9 |
| Gel | Mass Content of Elements in the Dispersed Phase/Gel, Found (wt.%) | Relative Content of Elements in Dispersed Phase, Relative % | ||||||
|---|---|---|---|---|---|---|---|---|
| Si | Fe | Zn | B | Si | Fe | Zn | B | |
| Si-Fe–Gel | 1.92/2.56 | 1.53/1.51 | − | − | 75 | 101 | − | − |
| Si-Fe-Zn–Gel | 1.21/1.51 | 0.75/0.74 | 1.68/1.70 | − | 80 | 101 | 99 | − |
| Si-Fe-B–Gel | 1.23/1.58 | 0.73/0.75 | − | 0.04/0.65 | 78 | 97 | − | 6 |
| Si-Fe-Zn-B–Gel | 1.34/1.74 | 0.84/0.86 | 0.76/0.97 | 0.07/0.39 | 77 | 98 | 78 | 18 |
| Test Culture | Zone of Inhibition (mm) * | ||||
|---|---|---|---|---|---|
| Fe-Si–Gel ** | Si-Fe-Zn–Gel | Si-Fe-B–Gel | Si-Fe-Zn-B–Gel | Positive Control *** | |
| E. coli ATCC 8739 | 0 | 12.0 ± 0.5 | 11.0 ± 0.5 | 20.0 ± 0.5 | 18.5 ± 0.5 |
| P. aeruginosa ATCC 9027 | 0 | 10.0 ± 1.0 | 18.0 ± 1.0 | 22.0 ± 1.0 | 12.0 ± 0.5 |
| S. aureus ATCC 25923 | 13.0 ± 1.0 | 13.0 ± 1.0 | 21.0 ± 1.0 | 16.0 ± 1.0 | 38.0 ± 0.5 |
| S. aureus (MRSA) NCTC 12493 | 0 | 13.0 ± 1.5 | 20.0 ± 1.5 | 16.0 ± 1.5 | 41.0 ± 0.5 |
| S. aureus, clinical strain | 0 | 13.0 ± 1.5 | 21.5 ± 1.5 | 20.0 ± 1.5 | 41.0 ± 0.5 |
| S. aureus (MRSA), clinical strain | 12.5 ± 1.5 | 14.0 ± 1.5 | 22.0 ± 1.5 | 21.0 ± 1.5 | 38.0 ± 0.5 |
| S. pyogenes ATCC 19615 | 0 | 21.0 ± 1.0 | 20.0 ± 1.0 | 27.0 ± 1.0 | 38.0 ± 0.5 |
| C. albicans RCPF Y-401/NCTC-885-653 | 0 | 21.0 ± 1.0 | 25.0 ± 1.0 | 30.5 ± 1.0 | 30.0 ± 0.5 |
| Element | Found (Calculated) Mass Content of Elements in the Gel (wt.%) | |||
|---|---|---|---|---|
| Si-Fe–Gel | Si-Fe-Zn–Gel | Si-Fe-B–Gel | Si-Fe-Zn-B–Gel | |
| Si | 2.56 (2.45) | 1.51 (1.43) | 1.58 (1.55) | 1.74 (1.79) |
| Fe | 1.51 (1.46) | 0.74 (0.71) | 0.75 (0.77) | 0.86 (0.89) |
| Zn | − | 1.70 (1.66) | − | 0.97 (1.04) |
| B | − | − | 0.65 (0.60) | 0.39 (0.35) |
Disclaimer/Publisher’s Note: The statements, opinions and data contained in all publications are solely those of the individual author(s) and contributor(s) and not of MDPI and/or the editor(s). MDPI and/or the editor(s) disclaim responsibility for any injury to people or property resulting from any ideas, methods, instructions or products referred to in the content. |
© 2024 by the authors. Licensee MDPI, Basel, Switzerland. This article is an open access article distributed under the terms and conditions of the Creative Commons Attribution (CC BY) license (https://creativecommons.org/licenses/by/4.0/).
Share and Cite
Khonina, T.; Alekseenko, S.; Shadrina, E.; Ganebnykh, I.; Mekhaev, A.; Larionov, L.; Dobrinskaya, M.; Izmozherova, N.; Antropova, I.; Karabanalov, M.; et al. Hemostatic Antimicrobial Hydrogels Based on Silicon, Iron, Zinc, and Boron Glycerolates for Wound Healing Applications. Gels 2024, 10, 795. https://doi.org/10.3390/gels10120795
Khonina T, Alekseenko S, Shadrina E, Ganebnykh I, Mekhaev A, Larionov L, Dobrinskaya M, Izmozherova N, Antropova I, Karabanalov M, et al. Hemostatic Antimicrobial Hydrogels Based on Silicon, Iron, Zinc, and Boron Glycerolates for Wound Healing Applications. Gels. 2024; 10(12):795. https://doi.org/10.3390/gels10120795
Chicago/Turabian StyleKhonina, Tat’yana, Semyon Alekseenko, Elena Shadrina, Il’ya Ganebnykh, Alexander Mekhaev, Leonid Larionov, Maria Dobrinskaya, Nadezhda Izmozherova, Irina Antropova, Maxim Karabanalov, and et al. 2024. "Hemostatic Antimicrobial Hydrogels Based on Silicon, Iron, Zinc, and Boron Glycerolates for Wound Healing Applications" Gels 10, no. 12: 795. https://doi.org/10.3390/gels10120795
APA StyleKhonina, T., Alekseenko, S., Shadrina, E., Ganebnykh, I., Mekhaev, A., Larionov, L., Dobrinskaya, M., Izmozherova, N., Antropova, I., Karabanalov, M., Kokhan, M., Evstigneeva, N., & Chupakhin, O. (2024). Hemostatic Antimicrobial Hydrogels Based on Silicon, Iron, Zinc, and Boron Glycerolates for Wound Healing Applications. Gels, 10(12), 795. https://doi.org/10.3390/gels10120795

